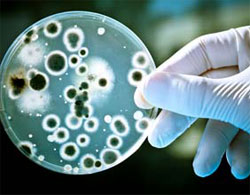

Uitaţi de amprentele digitale: puteţi fi identificaţi prin intermediul «norului dumneavoastră microbian»
Fiecare persoană emite un amestec unic de microbi în aer şi acest „nor microbian” este suficient de personalizat încât să poată fi folosit pentru a identifica persoana care l-a emis, a descoperit un nou studiu.
Fiecare persoană emite un amestec unic de microbi în aer şi acest „nor microbian” este suficient de personalizat încât să poată fi folosit pentru a identifica persoana care l-a emis, a descoperit un nou studiu.
Rezultatele „demonstrează pentru prima dată că oamenii degajă un nor microbian personal”, a declarat James Meadow, conducătorul studiului. Trilioane de bacterii trăiesc pe şi în trupul uman. Împreună, aceste bacterii formează ceea ce cercetătorii numesc microbiomul uman, adică mulţimea de microbi ataşaţi trupului fiecăruia dintre noi.
Studii anterioare au descoperit că cel puţin trei surse contribuie la norul de bacterii care se află în jurul nostru: praful, emisiile din haine şi emisiile persoanei respective, afirmă cercetătorii într-un studiu publicat în 22 septembrie 2015 (Body Bugs: 5 Surprising Facts About Your Microbiome).
În cadrul noului studiu, cercetătorii au rugat participanţii să stea singuri într-o cameră sterilă, cu aer filtrat. Pentru a reduce numărul particulelor provenite de la haine, fiecaruia dintre ei i s-au dat haine noi curate, identice. Participanții au stat într-un scaun cu rotile, de plastic, care fusese dezinfectat în prealabil şi au primit câte un laptop sterilizat pentru a comunica cu cercetătorii care se aflau în afara camerelor respective (participanţilor li s-a permis să folosească laptopul şi pentru divertisment), explică autorii studiului.
Toate particulele provenite de la subiecții studiului au fost direcţionate afară din cameră cu ajutorul filtrelor, apoi au fost colectate şi analizate genetic. Cercetătorii au folosit secvenţele genice obţinute pentru a identifica bacteriile.
Într-unul dintre experimente, cercetătorii au comparat aerul din cameră cu cel dintr-o cameră învecinată, neocupată. Trei persoane au participat la acest experiment şi fiecare a rămas în cameră timp de patru ore, a ieșit pentru a lua o pauză şi apoi a revenit pentru alte două ore.
După două ore, cercetătorii au descoperit că puteau determina dacă o persoană a fost prezentă în cameră, doar analizând bacteriile din probele obţinute.
 Cercetătorii au mai observat că amestecurile de bacterii care înconjurau fiecare persoană puteau fi uşor diferenţiate, astfel că au realizat un al doilea experiment pentru a vedea cât de bine pot fi identificate fiinţele umane cu ajutorul norului lor bacterian unic.
Cercetătorii au mai observat că amestecurile de bacterii care înconjurau fiecare persoană puteau fi uşor diferenţiate, astfel că au realizat un al doilea experiment pentru a vedea cât de bine pot fi identificate fiinţele umane cu ajutorul norului lor bacterian unic.
În al doilea experiment, opt persoane diferite de cele care deja participaseră prima oară au fost rugate să stea în cameră pentru două perioade de 90 de minute. „Ne aşteptam să putem detecta microbiomul uman în aerul din jurul unei persoane, dar am fost surprinşi să descoperim şi faptul că i-am putut identifica pe majoritatea ocupanților camerei doar cu ajutorul norului microbian”, a declarat Meadow, cercetător în studii postdoctorale la Universitatea Oregon din Statele Unite ale Americii.
Cercetătorii au descoperit că principalele tipuri de bacterii din „norii” persoanelor erau bacterii asociate omului, aparținând genului Streptococcus, care se află în mod obişnuit în gură, precum şi genurilor Propionibacterium şi Corynebacterium, care se găsesc de obicei pe piele. În cazul femeilor participante la experiment, cercetătorii au observant de asemenea și prezenţa în norul microbian a unor bacterii vaginale obișnuite.
Deşi rezultatele studiului sugerează că descoperirile pot fi utilizate în criminalistică, cercetătorii au avertizat că sunt necesare studii suplimentare, deoarece șabloanele pe care le-au descoperit „pot fi mult mai nuanţate în cazul unei mulţimi de oameni, într-un spaţiu mult mai mare sau în prezenţa prafului resuspendat în atmosfera camerei”.
Pe lângă aceste aspecte trebuie, de asemenea, luați în considerare și toţi microbii lăsaţi în urmă de companionii noştri non-umani.
Citiți și:
Scanere de amprente digitale fără contact – pot surprinde amprentele de la metri distanță
Psihometria, capacitatea paranormală de a «citi» obiectele (1)
yogaesoteric
3 decembrie 2015
